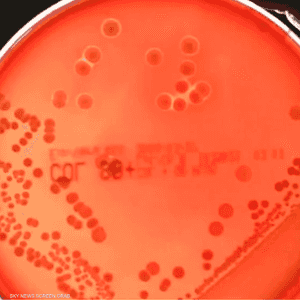
التهاب الحلق واحد من الأعراض الشائعة للمكورات العنقودية

بريطانيا تسجل وفاة ثامن طفل نتيجة المكورات العنقودية "آي"
23:55 - 05 ديسمبر 2022
توفي طفل جديد في بريطانيا، الاثنين، بعدما جرى تشخيص إصابته ببكتيريا المكورات العنقودية "آي".
ومع هذه الوفاة، ترتفع إلى 8 حصيلة وفيات بكتيريا المكورات العنقودية "آي" خلال الأسابيع الأخيرة في بريطانيا.
وكانت البلاد سجلت قبل ساعات الوفاة رقم 7 بسبب هذه العدوى، وهي لطفل يبلغ من العمر 12 عاما في لندن.
وذكرت شبكة "سكاي نيوز" البريطانية، مساء الاثنين، أن الضحية الجديدة رقم 8 هي طالب في مدرسة أساسية في مقاطعة هامبشاير، جنوب بريطانيا.
وانتشر شكل معد للغاية من العدوى البكتيرية "آي" في شتى أنحاء بريطانيا خلال الأشهر الأخيرة، مع تحذير الحكومة البريطانية للأهالي بأن يكون يقظين في مواجهة الأعراض التي تظهر على أطفالهم.
ومع ذلك، أكدت أن هيئة الخدمات الصحية في البلاد "أن أتش سي" مهيئة بشكل جيد لمواجهة تفشي العدوى، مؤكدة أنه لا يوجد أي نقص في المضاد الحيوي الذي يحارب هذه المشكلة الصحية.
وتسبب هذه العدوى التهابا في الحلق وحمى تؤدي إلى طفح جلدي، وتحدث نتيجة الاتصال الجسدي أو من قطرات العطس والسعال.
وحذرت السلطات من أن الأشخاص الذين تزيد أعمارهم عن 65 عاما، أو أولئك المصابين بفيروس نقص المناعة "الإيدز"، أو الذين يستخدمون المنشطات، أو الذين يعانون من مرض السكري أو أمراض القلب أو السرطان هم الأكثر عرضة للإصابة بالعدوى إلى جانب الأطفال.